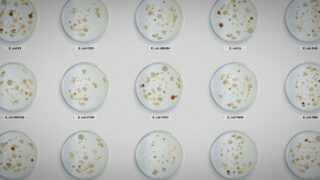

Wir alle tun es, täglich, die meisten sogar mehrfach pro Tag: essen. Unsere Körper sind darauf angewiesen, dass wir ihnen regelmäßig Nahrung zuführen und mit dem versorgen, was sie brauchen. Dabei sind wir uns oft nicht wirklich bewusst, was wir da in uns hineinstecken. Vor allem sind wir uns der Gefahren nicht bewusst. Früher war es normal, dass Lebensmittel immer ein Risiko bedeuteten. Inzwischen sind dank Regulierungen, Kontrolle und allgemeinen verbesserten Möglichkeiten die Risiken so stark gesunken, dass wir sie gar nicht mehr wahrnehmen. Umso schockierender ist, wenn doch wieder etwas geschieht. Der Netflix-Dokumentarfilm Vergiftet: Die schmutzige Wahrheit über unser Essen erinnert daran, indem er ein paar besonders tragische Fälle vorstellt.
Das tragische Geschäft mit dem Tod
Genauer wird erzählt, wie Salat und Fleisch von Keimen befallen waren. Das Ergebnis war fatal, in Folge wurden mehrere Menschen schwer krank. Einige kostete es sogar das Leben. Besonders zu Herzen gehen dabei natürlich die Fälle, bei denen Kinder sterben mussten. Wer rechnet schon damit, dass der Besuch bei einer Fast-Food-Kette dir dein Kind nehmen könnte? Leider belässt es der Film dabei nicht einfach damit, neutral von diesen Ereignissen zu berichten. Stattdessen zeigt Regisseurin Stephanie Soechtig bei Vergiftet: Die schmutzige Wahrheit über unser Essen einen unangenehmen Hang zum Voyeurismus und zur Manipulation. Da wird gnadenlos das Publikum in die emotionale Zange genommen, wohl wissend, dass tote Kinder immer eine Wirkung zeigen.
Ein weiteres Manko ist, dass der Film nicht wirklich an einer unvoreingenommenen Auseinandersetzung mit dem Thema interessiert ist. Vielmehr handelt es sich bei der Dokumentation um eine, deren Ergebnis am Anfang schon feststeht. Und dieses Ergebnis lautet, dass die Lebensmittelindustrie ihren Pflichten nicht nachkommt und des Profits wegen die Gesundheit der Menschen aufs Spiel setzt. So etwas zieht immer, Unternehmen sind ideale Feindbilder. Während aber beispielsweise der Spielfilm Les algues vertes über schmutzige Machenschaften in der Landwirtschaft zumindest streckenweise darum bemüht war, auch die Gegenseite zu Wort kommen zu lassen und die Komplexität der Situation zu veranschaulichen, da macht man es sich bei Vergiftet: Die schmutzige Wahrheit über unser Essen einfach. Zwischendurch darf eine Frau die anderen vertreten. Das geht aber nur wenige Minuten, ansonsten hat ein Anwalt das Sagen, der geschädigte Familien vertritt.
Wichtige Fragen, oberflächlich behandelt
Das bedeutet aber nicht, dass der Film nichts zur Debatte beizutragen hätte. So stellt er zumindest implizit wichtige Fragen etwa zur Selbstverantwortung der Einzelnen. Und natürlich auch: Wie viel ist uns unsere Sicherheit und unsere Gesundheit wert? Wären wir bereit, im Zweifel mehr für unser Essen auszugeben als heute, wenn dadurch gewährleistet wäre, dass es zu keinen Vorfällen mehr kommt? Wenn die Bedingungen in der Lebensmittelindustrie zum Teil haarsträubend sind, wie uns Vergiftet: Die schmutzige Wahrheit über unser Essen vor Augen führt, dann hat das natürlich auch wirtschaftliche Gründe. An der Stelle wäre es daher spannend gewesen, noch tiefer zu bohren, sich vielleicht auch mal mit Experten und Expertinnen zu unterhalten, die weder zu den Opfern noch zur Industrie gehören.
Stattdessen beschränkt sich der Film darauf zu sagen, dass die Argumente der Industrie keine sind, dass es sich nur um Ausreden handelt. Das darf man natürlich, ist in der Form aber etwas dünn. Vergiftet: Die schmutzige Wahrheit über unser Essen ist eine dieser Dokus, die knallhart auf den Skandalfaktor setzen, um damit ein Publikum aufzurütteln. Wer dafür empfänglich ist, wird sich der Wirkung kaum entziehen können. Man muss sich nur darauf einstellen, dass es hierbei weniger um Aufklärung geht, sondern man im Stil diverser Umweltdokus der letzten Jahre eine klare Aussage und Absicht verbunden ist, wie der reißerische Titel bereits vorwegnimmt.
OT: „Poisoned: The Dirty Truth About Your Food“
Land: USA
Jahr: 2023
Regie: Stephanie Soechtig
Drehbuch: Jeff Benedict
Ihr seid mit Vergiftet: Die schmutzige Wahrheit über unser Essen schon durch und braucht Nachschub? Dann haben wir vielleicht etwas für euch. In unserem Netflix-Themenbereich sind hunderte Original-Produktionen gelistet, unterteilt nach Spielfilm, Serie, Doku und Comedy. Unten findet ihr alle Netflix-Titel, die wir auf unserer Seite besprochen haben.
- 10 Dance
- 10 Tage eines guten Mannes
- 10 Tage eines neugierigen Mannes
- 10 Tage eines schlechten Mannes
- 1000 km weit weg von Weihnachten
- 11M: Terror in Madrid
- 13 – Das Musical
- 13 Gebote – Staffel 1
- 13. November: Angriff auf Paris
- 14 Gipfel: Nichts ist unmöglich
- 1670 – Staffel 1
- 180
- 1899 – Staffel 1
- 1922
- 1992
- 22. Juli
- 24 Stunden mit Gaspar
- 27 Nächte
- 28 Days Haunted
- 3 Body Problem – Staffel 1
- 3 von oben: Geschichten aus Arcadia – Teil 1
- 365 Days
- 365 Days: Dieser Tag
- 365 Days: Noch ein Tag
- 37 Seconds
- 42 Tage ohne Spur – Staffel 1
- 50 m2 – Staffel 1
- 53 Sonntage
- 6 Ballons
- 6 Underground
- 60 Minuten
- 7 Donne e un Mistero
- 7 Gefangene
- 8 Rue de l’Humanité
- 84 m2
- 900 Tage ohne Anabel
- A Babysitter’s Guide to Monster Hunting
- A Beautiful Life
- A California Christmas
- A California Christmas: City Lights
- A Castle for Christmas
- A Christmas Prince
- A Christmas Prince: The Royal Baby
- A Christmas Prince: The Royal Wedding
- A Classic Horror Story
- A Fall from Grace
- A Family Affair
- A House of Dynamite
- A Jazzman’s Blues
- A Journey
- A Killer Paradox – Staffel 1
- A Land Imagined
- A Madea Homecoming
- A Merry Little Ex-Mas
- A Model Family
- A Perfect Pairing
- A Second Chance: Rivals!
- A Soweto Love Story
- A Tourist’s Guide to Love
- A Trip to Infinity
- A Week Away
- A World Without
- Aaahh Belinda
- Abenteuer ‘Ohana
- Abenteuer au pair
- Abercrombie & Fitch: Aufstieg und Fall
- Absolute Anfänger
- Absturz: Der Fall gegen Boeing
- Achtsam Morden – Staffel 1
- Ad Vitam (2025)
- Adolescence (2025)
- Adú
- After Life (2019)
- Against the Ice
- Agatha Christie’s Seven Dials
- Agent from Above – Staffel 1
- Aggretsuko – Staffel 1
- Aggretsuko: We Wish You a Metal Christmas
- Aileen: Queen of the Serial Killers
- AJ and the Queen – Staffel 1
- Ajin: Demi-Human – Staffel 1
- AKA
- aka Charlie Sheen
- Akuma Kun – Staffel 1
- Alex Strangelove
- Alexander der Große: Wie er ein Gott wurde
- Ali’s Wedding
- Alice in Borderland – Staffel 1
- Alien Xmas
- All Day and a Night
- All die verdammt perfekten Tage
- All In My Family
- All of Us Are Dead
- All Together Now
- Alle Sommersprossen der Welt
- Alles für die Liebe – Staffel 1
- Alles Gute kommt von oben
- Alles Licht, das wir nicht sehen
- Alles nur eine Frage des Geschmacks
- Alma – Staffel 1
- Almost Cops
- Alphamännchen – Staffel 1
- AlRawabi School for Girls
- Als ich als Vampir aufwachte – Staffel 1
- Als mein Vater Weihnachten rettete 2
- Alte Zöpfe
- Altes Geld, neue Liebe – Staffel 1
- Always Be My Maybe
- Am Flussufer
- Am helllichten Tag: Mord in Narvarte
- Amandla
- Amateur
- America: Der Film
- American Conspiracy: The Octopus Murders
- American Factory
- American Manhunt: Der Anschlag auf den Boston-Marathon
- American Manhunt: O.J. Simpson
- American Manhunt: Osama Bin Laden
- American Murder: Die Bilderbuchfamilie
- American Murder: Gabby Petito
- American Murder: Laci Peterson
- American Primeval
- American Son
- Amsterdam Empire – Staffel 1
- Amy Bradley ist spurlos verschwunden
- An ihrer Stelle
- Anatomie eines Skandals
- Angelas Weihnachten
- Angelas Weihnachtswunsch
- Angi: (K)eine perfekte Mörderin
- Angriff der Hollywood-Klischees!
- Anikulapo
- Animalisch – Staffel 1
- Animas
- Anleitung für einen Drogenskandal
- Anna Nicole Smith: You Don't Know Me
- Anne+: Der Film
- Anónima – Nachricht von Unbekannt
- Another Life – Staffel 1
- Anthracite
- Antoine Griezmann – Eine Legende wird geboren
- Apex (2026)
- Apokalypse in den Tropen
- Apollo 10 1/2: Eine Kindheit im Weltraumzeitalter
- Apollo 13: Überleben
- Apostle
- Apple Cider Vinegar
- Arbeit: Was wir den ganzen Tag machen
- Archive 81 – Staffel 1
- Arctic Justice: Thunder Squad
- Ares – Staffel 1
- Arlo, der Alligatorjunge
- Army of the Dead
- Army of Thieves
- Arnold
- ARQ
- As You Stood By
- Asaf
- Asakusa Kid
- Asche
- Ashley Madison: Sex, Lügen und der Skandal
- Asphalt Burning
- Asterix & Obelix: Der Kampf der Häuptlinge
- Astrologischer Leitfaden für gebrochene Herzen – Staffel 1
- Atemlos – Staffel 1
- Athena
- Atiye – Die Gabe – Staffel 1
- Atiye – Die Gabe – Staffel 2
- Atlantique
- Atlas (2024)
- Auf meiner Haut
- Auf Teufel komm raus: Die wilde Welt des John McAfee
- Auge um Auge (2019)
- Augen zu und durch, Bruder
- Aurora
- Auslöschung
- Außer Kontrolle (2025)
- Avatar: Der Herr der Elemente – Staffel 1 (2024)
- Avicii – Ich heiße Tim
- Awake (2021)
- Away – Staffel 1
- Babamin Kemani – Die Geige meines Vaters
- Babo – Die Haftbefehl-Story
- Bac Nord – Bollwerk gegen das Verbrechen
- Back in Action
- Back Street Girls -GOKUDOLS-
- Bad Influence: Die Schattenseite von Kidfluencing
- Bad Surgeon: Liebe unter dem Messer
- Bad Trip
- Bad Vegan: Berühmt und betrogen
- Badland Hunters
- Baggio: Das göttliche Zöpfchen
- Bajocero (Unter Null)
- Baki Hanma VS Kengan Ashura
- Baking Impossible – Staffel 1
- Ballad Of A Small Player
- Ballerina (2023)
- Banden von Marseille
- Bandi – Unter Geschwistern – Staffel 1
- Bandidos
- Banger (2025)
- Bank unter Belagerung
- Banlieusards – Du hast die Wahl
- Banlieusards 2
- Banlieusards 3
- Barbara – Becoming Shirin David
- Barbaren – Staffel 1
- Bardo, die erfundene Chronik einer Handvoll Wahrheiten
- Barracuda Queens – Staffel 1
- Bartkowiak
- Bastion 36
- Battle
- Battle: Freestyle
- Beastars – Staffel 1
- Beats
- Beauty
- Beauty and the Bester
- Beauty in Black – Staffel 1
- Because of You
- Beckett
- Beckham
- Beef – Staffel 1
- Been So Long
- Begründeter Zweifel: Die Geschichte zweier Entführungen
- Being Eddie
- Beirut
- Bekenntnisse eines unsichtbaren Mädchens
- Belascoarán, Privatdetektiv – Staffel 1
- Believer 2
- Benji
- Berlin und die Dame mit dem Hermelin
- Berlin, Berlin – Der Film
- Bernie Madoff: Das Monster der Wall Street
- Bescheidene Helden: Ponoc Short Films Theatre
- Best. Christmas. Ever!
- Betonrausch
- Betrügerische Liebe
- Better Than Us – Staffel 1
- Beverly Hills Cop: Axel F
- Bhakshak
- Big Mäck: Gangster und Gold
- Big Mistakes – Staffel 1
- Big Mouth – Staffel 1
- Bigbug
- Biggest Heist Ever – Der große Bitcoin-Raub
- Bikram: Yogi, Guru, Raubtier
- Biohackers – Staffel 1
- Bionische Schwestern
- Bird Box – Schließe deine Augen
- Bird Box: Barcelona
- Bis zum Morgengrauen – Staffel 1
- Bis zum Untergang
- Bitconned – Der Betrug mit der Cryptowährung Centra
- Bitterer Wodka und süße Küsse
- Black Clover: Sword of the Wizard King
- Black Doves – Staffel 1
- Black Earth Rising
- Black Mirror: Bandersnatch
- Black Rabbit
- Black Spot – Staffel 1
- Black Summer – Staffel 1
- Blame! (2017)
- Blasted
- Bleach (2018)
- Blond
- Blood & Gold
- Blood & Water – Staffel 1
- Blood & Water – Staffel 2
- Blood Red Sky
- Blood Sisters
- Blood Vessel
- Bloodhounds – Staffel 1
- Blue Miracle
- Blutiger Trip – Staffel 1
- Blutsbrüder: Malcolm X und Muhammad Ali
- Bodies
- Bodkin
- Bodyguard – Staffel 1
- Boğa Boğa
- Bogotá: Stadt der Verlorenen
- Boi
- Bombay Rose
- Bonding – Staffel 1
- Bonjour Agneta
- Boo, Bitch
- Boots – Staffel 1
- Borgen: Macht und Ruhm – Staffel 1
- Böses Spiel – Staffel 1 (Folgen 1-4)
- Boxer
- Boy Swallows Universe
- Brand New Cherry Flavor
- Break
- Break Point – Teil 1
- Brews Brothers – Staffel 1
- Brick (2025)
- Bridgerton – Staffel 1
- Briefe an die Zukunft
- Briganti: Das Gold des Südens
- Broad Peak
- Broken Idol: Das Vergehen des Diomedes Díaz
- Brotherhood: Angstzustand
- Bruised
- Buba
- Bubble
- Budapest
- Bulbbul
- Bullet Train Explosion
- Bullsh*t: Die Quizshow – Staffel 1
- Burn Out
- Buy My House – Staffel 1
- Buy Now! The Shopping Conspiracy
- Buying Beverly Hills – Staffel 1
- Caïd (Gangsta) – Staffel 1
- Calibre – Weidmannsunheil
- Cam
- Cambridge Analyticas großer Hack
- Candy Jar
- Capitani – Staffel 1
- Captain Fall – Staffel 1
- Captain Nova
- Captain Underpants und das riesige Auswahl-O-Rama
- Capturing the Killer Nurse
- Caramelo
- Cargo
- Carlo & Malik – Staffel 1
- Carmen Sandiego – Staffel 1
- Carnaval
- Carry-On
- Carter
- Cashero
- Cassandra
- Castlevania – Staffel 1
- Castlevania – Staffel 2
- Castlevania – Staffel 3
- Castlevania: Nocturne – Staffel 1
- Catching Feelings
- Catching Killers – Staffel 1
- Centauro
- Chambers – Staffel 1
- Champagne Problems
- Chaos: Die Manson-Morde
- Chicken Run: Operation Nugget
- Child of Kamiari Month
- Chilling Adventures of Sabrina – Staffel 1
- Choose or Die
- Chopsticks
- Chosen – Staffel 1
- Christmas Flow – Staffel 1
- Christmas With You
- Christopher – A Beautiful Real Life
- Chupa
- Churchill im Krieg
- Cities of Last Things
- City Hunter (2024)
- City of Joy
- Clans – Staffel 1
- Clark
- Clickbait
- Cobra Kai – Staffel 1
- Cobra Kai – Staffel 2
- Cobra Kai – Staffel 3
- Code 8 – Teil II
- Code des Verbrechens – Staffel 1
- Codename 13
- Codewort: Kaiser
- Coffee & Kareem
- Cold Case: Die Tylenol-Morde
- Cold Case: Wer ermordete JonBenét Ramsey?
- Colonia Dignidad: Eine deutsche Sekte in Chile
- Come Sunday
- Con Mum: Lang vermisste Mutter oder Betrügerin
- Concrete Cowboy
- Contigo Capitán
- Contra las cuerdas – Staffel 1
- Copenhagen Cowboy
- Copshop
- Copycat Killer – Staffel 1
- Cortafuego – Umgeben von Feuer
- Cosmic Princess Kaguya!
- Country Comfort – Staffel 1
- Crack: Kokain, Korruption und Konspiration
- Cracow Monsters – Staffel 1
- Crazyhead – Staffel 1
- Crime Scene Berlin: Nightlife Killer
- Crime Stories: India Detectives – Staffel 1
- Criminal: Deutschland – Staffel 1
- Criminal: Frankreich – Staffel 1
- Criminal: Vereinigtes Königreich – Staffel 1
- Crooks – Staffel 1
- Crypto Boy
- Curon – Staffel 1
- Cursed – Die Auserwählte – Staffel 1
- Curtiz
- Cyberbunker: Darknet in Deutschland
- Cyntoia Brown: Die Geschichte einer begnadigten Mörderin
- Da 5 Bloods
- Dad Stop Embarrassing Me! – Staffel 1
- Dahmer – Monster: Die Geschichte von Jeffrey Dahmer
- Damsel
- Dance 100 – Staffel 1
- Dance Brothers – Staffel 1
- Dancing Queens
- Dangerous Lies
- Danke – Nächster! – Staffel 1
- Danke, es tut mir leid
- Daredevil – Staffel 1
- Daredevil – Staffel 2
- Darf ich dir ein Geheimnis verraten?
- Dark – Staffel 1
- Dark Tourist
- Das antisoziale Netzwerk: Memes, Verschwörungstheorien und Gewalt
- Das Damengambit
- Das Dilemma mit den sozialen Medien
- Das dritte Auge
- Das dritte Auge 2
- Das Euro-Finale: Angriff auf Wembley
- Das fantastische Leben des Ibelin
- Das Festival der Troubadoure
- Das Football-Rätsel: Aaron Rodgers
- Das geheime Leben der Orang-Utans
- Das Geheimnis des Flusses
- Das Geschäft mit Drogen
- Das Gesetz des Dschungels – Staffel 1
- Das Gesetz nach Lidia Poët – Staffel 1
- Das Gift
- Das Glück hat acht Arme
- Das Grab im Wald
- Das Grenfell-Feuer – Was wirklich geschah
- Das gruselige Abenteuer des Captain Underpants: Hack-O-Ween
- Das Hausboot (2021)
- Das Herz des Jägers
- Das Interview mit Rosa Peral
- Das Leben ist wie ein Stück Papier
- Das letzte Wort – Staffel 1
- Das Letzte, was er wollte
- Das Leuchten der Rentiere
- Das machst du schon
- Das Mädchen auf dem Bild
- Das Mädchen aus Oslo – Staffel 1
- Das Mädchen im Schnee
- Das Mädchen und ihr Roboter – Die nächste Generation
- Das Monster von Florenz
- Das Motiv
- Das Museum der Unschuld
- Das Privileg – Die Auserwählten
- Das Programm: Hinter den Kulissen der Disziplinierungsindustrie
- Das Rätsel um D. B. Cooper
- Das Redeem-Team
- Das Reservat
- Das schaurige Haus
- Das Schweigen brechen: Der Fall Maria Soledad
- Das Schweigen des Sumpfes
- Das Seehund-Team
- Das Seeungeheuer
- Das Signal
- Das Spiel
- Das Tier – Staffel 1
- Das Unglück – Staffel 1
- Das Universum – Staffel 1
- Das verlorene Piratenreich – Staffel 1
- Das Vermächtnis des Weißwedelhirschjägers
- Das Wunder
- Das Zeichen des Teufels
- Dash & Lily – Staffel 1
- Dated & Related – Staffel 1
- Dating Around – Staffel 1
- David und die Weihnachtselfen
- Day Shift
- Daybreak – Staffel 1
- Dead Boy Detectives – Staffel 1
- Dead Kids
- Dead to Me – Staffel 1
- Dear Ex
- Dear White People – Ausgabe 1
- Death by Lightning
- Death to 2020
- Death to 2021
- Dein letztes Solo – Staffel 1
- Dein Zuhause gehört mir
- Deine Geschichte in Dragon Quest
- Deine letzte Stunde
- Delicious
- Demon City
- Dept. Q – Staffel 1
- Der Abgrund
- Der ägyptische Spion, der Israel rettete
- Der Apotheker
- Der Aufstieg der Teenage Mutant Ninja Turtles – Der Film
- Der Aufstieg von Weltreichen: Das osmanische Reich
- Der Auserwählte – Staffel 1 (2019)
- Der Auserwählte – Staffel 1 (2023)
- Der axtschwingende Anhalter
- Der Ball der 41
- Der Bankier des Widerstands
- Der Basar des Schicksals
- Der Baum des Blutes
- Der Befreier
- Der Biss der Klapperschlange
- Der Boden ist Lava – Staffel 1
- Der Bombenanschlag von Oklahoma City
- Der Brief für den König – Staffel 1
- Der Bus: Die Revolte der Les Bleus
- Der Champion
- Der Club – Staffel 1
- Der denkwürdige Fall des Mr Poe
- Der doppelte Vater
- Der Drache meines Vaters
- Der Duft des Goldes
- Der dunkle Kristall: Ära des Widerstands – Staffel 1
- Der Elefant des Magiers
- Der endlose Graben
- Der erste Blick, der letzte Kuss und alles dazwischen
- Der erste und der letzte Tag – Staffel 1
- Der Fall „Air Cocaine“: Schmuggler in 10.000 Meter Höhe
- Der Fall Alex Schwazer
- Der Fall Asunta
- Der Fall Fourniret: Im Kopf von Monique Olivier
- Der Fall Gabriel Fernandez
- Der Fall Jens Söring: Tödliche Leidenschaft
- Der Fall Lucy Letby
- Der Fall Nathan Carman
- Der Fall Outreau: Ein französischer Albtraum
- Der Fall Yara Gambirasio: Hinreichende Beweise
- Der Fälscher
- Der Fotograf und der Postbote: Der Mord an José Luis Cabezas
- Der Gärtner
- Der Gegenangriff
- Der Geist von Sultanpore
- Der göttliche João: Die Verbrechen eines Geistheilers
- Der Helicopter Coup
- Der Hooligan
- Der Imaginäre
- Der Jäger von Sevilla
- Der Jahrestag
- Der junge Wallander – Staffel 1
- Der Junge, der den Wind einfing
- Der Käfig – Staffel 1
- Der Kastanienmann – Staffel 1
- Der Killer
- Der König, der niemals einer war
- Der Kristallkuckuck
- Der Kurier (2024)
- Der Kurpfuscher
- Der Leopard (2025)
- Der letzte Paradiso
- Der letzte Sommer
- Der letzte Wolf von Lyssia – Staffel 1
- Der Liebesbetrug
- Der Mann mit 1000 Kindern
- Der Mann ohne Gravitation
- Der Mann, der UFOs liebte
- Der maskierte Betrüger
- Der Maulwurf – Staffel 1
- Der meistgehasste Mann im Internet
- Der Millennium-Raub
- Der Milliardärsbunker – Staffel 1
- Der Mord an Jill Dando
- Der Mord an Rachel Nickell
- Der Mörder in Aaron Hernandez
- Der Mörder meiner Tochter
- Der Parfumeur
- Der Pate von Bombay – Staffel 1
- Der Preis der Versuchung
- Der Prinz der Drachen – Staffel 1
- Der Puppenspieler: Auf der Jagd nach dem ultimativen Betrüger
- Der Rattenfänger
- Der Regenmantel-Killer: Mörderjagd in Korea
- Der Sanitäter
- Der Schacht 2
- Der Schatz des Duce
- Der schlimmste Mitbewohner aller Zeiten
- Der Schneider – Staffel 1
- Der Schwan
- Der schwarze Brunnen
- Der schwarze Diamant
- Der Schwiegersohn
- Der Sohn von tausend Männern
- Der Spinnenkopf
- Der Teufel auf der Anklagebank
- Der Teufel soll dich holen
- Der Teufel wohnt nebenan
- Der tiefste Atemzug
- Der TikTok-Killer
- Der Tinder-Schwindler
- Der Tränenmacher
- Der Unbarmherzige
- Der unsichtbare Faden
- Der unsterbliche Brij Mohan
- Der Untergang des Hauses Usher
- Der unwahrscheinliche Mörder
- Der Ursprung der Welt
- Der Verbrauchermarkt: Ein kaputtes System – Staffel 1
- Der Vogel
- Der Vulkan: Rettung von Whakaari
- Der weiße Tiger
- Der Wendepunkt
- Der Widerspenstigen Zähmung
- Der Widerspenstigen Zähmung 2
- Der Wunschdrache
- Der Yorkshire Ripper
- Der Zweite Weltkrieg: Der Weg zum Sieg (in Farbe)
- Der Zweite Weltkrieg: Von der Front
- Designing Miami – Staffel 1
- Desperados
- Devil in Ohio
- Devil May Cry (2025) – Staffel 1
- Devilman Crybaby
- Devotion
- Diablero – Staffel 1
- Die 7 Bären – Staffel 1
- Die Abenteuer des Captain Underpants – Staffel 1
- Die Affäre Bettencourt: Skandal um die reichste Frau der Welt
- Die Akademie des Meisters Klex
- Die Alien-Entführung von Manhattan
- Die Åre-Morde – Staffel 1
- Die Augen von Marilyn
- Die Ausgrabung
- Die außergewöhnlichsten Häuser der Welt – Staffel 1
- Die Bande aus der Baker Street – Staffel 1
- Die Bestie
- Die Bleikinder
- Die Brüder Menendez
- Die bunte Seite des Mondes
- Die Casagrandes – Der Film
- Die Dame der Stille: Die Mataviejitas-Morde
- Die Dinosaurier
- Die Donnerstagswitwen
- Die drei Tode der Marisela Escobedo
- Die dunkle Seite der Kirche La Luz del Mundo
- Die Einkreisung
- Die Einöde
- Die Elefantenflüsterer
- Die Entführung des Fluges 601
- Die Erben der Erde – Staffel 1
- Die Erbschaft (2024)
- Die Familie Claus
- Die Familie Claus 2
- Die Familie Claus 3
- Die Figo-Affäre: Der Transfer, der den Fußball veränderte
- Die Flummel
- Die Frauen und der Mörder
- Die Gangster Gang: Aller Anfang ist böse
- Die Gangster Gang: Geisterhafte Gaunereien
- Die Gangster Gang: Schurkische Weihnachten
- Die geborgte Ehefrau
- Die Geldwäscherei
- Die Geschichte der Indrani Mukerjea: Begrabene Wahrheit
- Die Geschichte der Rachel Dolezal
- Die Geschichte der Schimpfwörter – Staffel 1
- Die Geschichte meiner Familie
- Die Geschichte zweier Küchen
- Die Gesetze der Thermodynamik
- Die Glaskuppel
- Die Gringo-Jäger – Staffel 1
- Die große Verführung (2023)
- Die Haiflüsterin
- Die härtesten Spezialeinheiten der Welt
- Die Haut des Wolfes
- Die heilende Kraft von Dude – Staffel 1
- Die Herrscher des Glücks – Staffel 1
- Die Insel der Küstenwölfe
- Die Jagd auf Veerappan
- Die Kaiserin – Staffel 1
- Die katholische Schule
- Die Kings von Tupelo: Eine Krimisaga im Süden der USA
- Die kleine Schweiz
- Die Köchin von Castamar – Staffel 1
- Die Krankenschwester
- Die Kreatur
- Die Kreidelinie
- Die Kunst des toten Mannes
- Die Kunst, ein Herz zu stehlen
- Die kuriosen Kreationen der Christine McConnell – Staffel 1
- Die längste Nacht
- Die legendäre Kokain-Insel
- Die Legende – Staffel 1
- Die Leinwand
- Die letzte Nacht in Tremor
- Die letzten Zaren
- Die Liebeskümmerer
- Die Löwinnen – Staffel 1
- Die Lüge
- Die magische Prank-Show mit Justin Willman – Staffel 1
- Die Mitchells gegen die Maschinen
- Die Münzraub-AG
- Die Murdaugh-Morde: Skandal in den Südstaaten – Staffel 1
- Die Murdaugh-Morde: Skandal in den Südstaaten – Staffel 2
- Die Pokémon-Concierge – Staffel 1
- Die Schergen des Midas
- Die Schlacht um die Schelde
- Die Schlange
- Die Schneegesellschaft
- Die Schneeschwester
- Die schöne Rebellin
- Die schwarze Witwe (2025)
- Die schwedische Verbindung
- Die Schwimmerinnen
- Die statistische Wahrscheinlichkeit von Liebe auf den ersten Blick
- Die Stille des Todes
- Die Strafe Gottes
- Die Stunde der Mutigen
- Die Supermonster retten Halloween
- Die Supermonster retten Weihnachten
- Die Supermonster und der Wunschstern
- Die Supermonster: Monstermäßige Weihnachten
- Die Supermonster: Tierisch gute Freunde
- Die Todesschwester
- Die toten Frauen
- Die Trottels
- Die Turteltauben
- Die Unbekannte vom Hafen
- Die unglaubliche Geschichte der Roseninsel
- Die Unsterblichen – Staffel 1
- Die verborgenen Fähigkeiten unserer Haustiere – Staffel 1
- Die Verbrechen unserer Mutter
- Die verlorenen Kinder
- Die Vorteile des Betrogenwerdens
- Die Waffenruhe
- Die Wahrheit über Jussie Smollett?
- Die Walkinder – Staffel 1
- Die wandernde Erde
- Die Warnung
- Die Weihnachtskarte
- Die Welt der Drogen: Dope Stories – Staffel 1
- Die Welt gehört dir
- Die Weltuntergangssekte des Antares de la Luz
- Die Werwölfe von Düsterwald
- Die wilden Neunziger! – Staffel 1
- Die Woche
- Die Zeit, die ich dir widme – Staffel 1
- Die zwei Päpste
- Die zwölf Geschworenen – Staffel 1
- Diebinnen
- Diebische Elstern – Staffel 1
- Dig Deeper: Das Verschwinden von Birgit Meier
- Diorama
- Diplomatische Beziehungen – Staffel 1
- Dirty John – Staffel 1
- Dirty Lines – Staffel 1
- Disco Inferno
- Disconnect: The Wedding Planner
- Disenchantment – Staffel 1
- DJ Cinderella
- Do Not Disturb
- Do Revenge
- Dog Gone
- Dolemite Is My Name
- Doll House
- Dolly Parton’s Christmas on the Square
- Don’t Die: Der Mann, der unsterblich sein will
- Don’t F**k with Cats – Die Jagd nach einem Internet-Killer
- Don’t Look Up
- Don’t Move
- Down for Love – Staffel 1
- Dr. Hwang Woo-suk, König der Klone
- Dr. Seuss: Die Schnipfen
- Dr. Seuss: Rotfisch, Blaufisch – Staffel 1
- Dracula (2020)
- Dream
- Drei Leben
- Drei Meter über dem Himmel – Staffel 1
- Drei Töchter
- Drifting Home
- Drink Masters – Staffel 1
- Drive (2019)
- Drive Hard: The Maloof Way – Staffel 1
- Dschinn – Staffel 1
- Dschungel Beat – Der Film
- Du bist es
- Du bist nicht allein: Kampf gegen das Wolfsrudel
- Du bist sowas von nicht zu meiner Bat-Mizwa eingeladen
- Du bist, was du isst: Ein Zwillingsexperiment
- Du gegen die Wildnis – Abgestürzt
- Du gegen die Wildnis – Der Film
- Du gegen die Wildnis – Staffel 1
- Du hast das Leben vor dir
- Du Sie Er & Wir
- Dude
- Dumplin’
- Dying to Tell
- Earthstorm: Naturgewalten auf der Spur – Staffel 1
- Easy-Bake Battle: The Home Cooking Competition – Staffel 1
- Eat Pray Bark
- Echoes (2022)
- Ehrengard: Die Geschichte einer Verführung
- Ein amerikanischer Albtraum
- Ein anderes Selbst – Staffel 1
- Ein besonderes Leben – Staffel 1
- Ein echter Gentleman
- Ein ehrliches Leben
- Ein Freund, ein Mörder
- Ein ganz mieser Tag
- Ein ganzer Kerl
- Ein klitzekleines Weihnachtswunder
- Ein Mädchen und ein Kosmonaut – Staffel 1
- Ein Mann der Tat
- Ein Mordsteam ermittelt wieder
- Ein neuer Sommer
- Ein Polizei-Film
- Ein Sturm zu Weihnachten
- Ein Teil von dir
- Ein Teil von ihr
- Ein tierischer Zirkus
- Ein unsichtbares Opfer: Der Fall Eliza Samudio
- Ein zu kurzes Leben: Der Fall Isabella Nardoni
- Ein Zug voller Hoffnung
- Eine dem Untergang geweihte Liebe
- Eine dunkle & grimmige Geschichte – Staffel 1
- Eine Gorilla-Story erzählt von David Attenborough
- Eine Handvoll Worte
- Eine kleine Liebesgeschichte
- Eine Kopenhagener Liebesgeschichte
- Eine Nacht im Kindergarten
- Eine perfekte Geschichte
- Eineinhalb Tage
- Einer von sechs
- Einer wie keiner
- Einfach schwarz
- Einfach unheimlich – Staffel 1
- Einfach unheimlich – Staffel 2
- Einmal Hexe … – Staffel 1
- Einstein und die Bombe
- Eirik Jensen: Polizist oder Gauner?
- El Autor
- El Camino: Ein „Breaking Bad“-Film
- El Comediante
- El Conde
- El Hijo – Der Sohn
- El Reino: Dein Reich komme – Staffel 1
- El Último Vagón
- Elena weiß Bescheid
- Elfen – Staffel 1
- Eli
- Emergency NYC – Staffel 1
- Emily in Paris – Staffel 1
- Encounters
- End of the Road
- Endspiel
- Enola Holmes
- Enola Holmes 2
- Enter the Anime
- Entergalactic
- Enthüllungen zu Mitternacht – Staffel 1
- Entrevías – Staffel 1
- Equinox – Staffel 1
- Er kennt keine Gnade
- Erde und Blut
- Eric
- Erkenntnisse aus einem Schulmassaker: Briefe aus Dunblane
- Erkrankt
- Ermordet: Tatort Times Square
- Errementari: Der Schmied und der Teufel
- Erşan Kuneri – Staffel 1
- Es tut verdammt weh
- Es war einmal ein Verbrechen
- Es war Zeit
- Escape The Undertaker
- Escaping Twin Flames
- Eternauta – Staffel 1
- Eurovision Song Contest: The Story of Fire Saga
- Everything Now – Staffel 1
- Evil Genius
- Evil Influencer: Die Story von Jodi Hildebrandt
- Ewige Liebe
- Explained: Coronavirus
- Explained: Sex
- Exploding Kittens – Staffel 1
- Exterritorial
- Extinction (2018)
- Extremis
- F Is for Family – Staffel 1
- F*ck die Liebe nochmal
- Fair Play
- Faithfully Yours
- Fake oder Liebe? – Staffel 1
- Fall for Me
- Falling Inn Love
- Familia (2023)
- Familie um jeden Preis
- Familie Willoughby
- Familie, aber nur fast
- Familienanhang – Teil 1
- Family Switch
- Fanfic
- Fantacalcio – Fantasy Football war Schuld
- Farben des Bösen: Rot
- Farben des Bösen: Schwarz
- Fast & Furious: Spy Racers – Staffel 1
- Fatal Affair
- Fatal Seduction – Staffel 1
- Fate: The Winx Saga – Staffel 1
- Fatherhood
- Fatma – Staffel 1
- Fear Street – Teil 1: 1994
- Fear Street – Teil 2: 1978
- Fear Street – Teil 3: 1666
- Fear Street: Prom Queen
- Fearless – Babysitten ist Heldensache
- Feel Good – Staffel 1
- Feel the Beat
- Feria: Dunkles Licht – Staffel 1
- Feriencamp mit Mama
- Ferry
- Ferry 2
- Feuer im Kopf
- Feueralarm
- Feueralarm: Die Grube
- Fiasco
- Fierce
- Fiesta in der Räuberhöhle
- FIFA Uncovered
- Fight for Paradise: Wem kannst du trauen? – Staffel 1 (Folgen 1-4)
- Files of the Unexplained – Staffel 1
- Filme – Das waren unsere Kinojahre – Staffel 1
- Filmriss
- Find Me Falling
- Finding Her Edge – Staffel 1
- First Class – Staffel 1
- First Kill – Staffel 1
- First Match
- Fishbowl Wives – Staffel 1
- Fistful of Vengeance
- Fit for TV: The Reality of the Biggest Loser
- Five Star Chef – Staffel 1
- Fixed
- Flashback (2023)
- Flavors of Youth
- Flitterwochen mit meiner Mutter
- Florida Man
- Flug 3054: Eine vorhergesagte Tragödie
- Flugmodus
- Follow This – Staffel 1
- Followers – Staffel 1
- Forest of Piano – Staffel 1
- Forever Rich
- Forst
- Found
- Fractured
- Fragen Sie Ihren Arzt – Staffel 1
- Francisco Boix: Der Fotograf von Mauthausen
- Frankenstein (2025)
- Frankenstein’s Monster’s Monster, Frankenstein
- Frau im Dunkeln
- Freaks – Du bist eine von uns
- Fred und Rose West: Eine britische Horror-Story
- Free Bert – Staffel 1
- Freestyle
- French Lover
- Freud – Staffel 1
- Friends from College – Staffel 1
- Friendzone
- Frohe Schenknacht mit Elmo und Mark Rober
- From Dusk till Dawn – Staffel 1
- From Dusk till Dawn – Staffel 2
- From Scratch
- Fubar – Staffel 1
- Fühlt ihr meine Stimme?
- Fünffache Rache – Staffel 1
- Für immer Liebe²
- Für immer zwölf – Staffel 1
- Für Jojo
- Furie
- Furies (2024) – Staffel 1
- Furioza
- Furioza 2
- Fyre – The Greatest Party That Never Happened
- Game Over, Man!
- Gänsehaut um Mitternacht
- Garouden: Wie hungrige Wölfe
- Geek Girl – Staffel 1
- Gefährliche Liebschaften (2022)
- Geheime Anfänge
- Geheimes Magieaufsichtsamt
- Geheimnisse der Neandertaler
- Geiselnahme live: Der Fall Eloá Pimentel
- Genombrottet
- Gentefied – Staffel 1
- Geschichten einer Generation – mit Papst Franziskus
- Geschichten vom See: Willy und die Wächter des Sees
- Geschichtshappen – Staffel 1
- Geständnisse eines Mörders
- Ghost Stories (2020)
- Ghul
- Gibt es ein Leben nach der Party?
- Gift (2023)
- Ginny & Georgia – Staffel 1
- Gipfel der Götter
- Girls from Ipanema – Staffel 1
- Girls with Balls
- Gladbeck: Das Geiseldrama
- Glamorous – Staffel 1
- Glass Onion: A Knives Out Mystery
- Glitch – Staffel 1
- Glitter – Staffel 1
- Glória – Staffel 1
- Glühendes Feuer – Staffel 1
- GO! Eine unvergessliche Party
- God’s Favorite Idiot – Staffel 1
- Godzilla: Eine Stadt am Rande der Schlacht
- Godzilla: Planet der Monster
- Godzilla: The Planet Eater
- Gokarts
- Gold und Gier: Die Jagd nach Forrest Fenns Schatz
- Golden Kamuy (2024)
- Gone Girls: Der Serienmörder von Long Island
- Gönül – Herzenslied
- Good Girls – Staffel 1
- Good Grief
- Good News (2025)
- Good on Paper
- Good Sam
- Goodbye June
- Goyo
- Grand Army – Staffel 1
- Granizo
- Grass Is Greener
- Griselda
- Groll
- Groom & Two Brides
- GTMAX
- Gudetama: An Eggcellent Adventure – Staffel 1
- Guillermo del Toro’s Cabinet of Curiosities – Staffel 1
- Guillermo Del Toros Pinocchio
- Gun City
- Gundam: Requiem for Vengeance – Staffel 1
- Gunthers Millionen
- Gute Reise
- Haarige Angelegenheiten
- Hack My Home – Staffel 1
- Hack Your Health: Die Geheimnisse unserer Verdauung
- Halb Malmö hat mit mir Schluss gemacht – Staffel 1
- Halston
- Hammerharte Jungs
- Handbuch einer Anstandsdame – Staffel 1
- Happy Ending
- Happy Gilmore 2
- Happy Nous Year
- Happy! – Staffel 1
- Harry & Meghan
- Harry Styles. One Night In Manchester.
- Hart am Wind
- Hätte ich dich nicht getroffen ...
- Haus der Geheimnisse: Die Toten von Burari
- Haus des Geldes: Berlin
- Haus des Geldes: Korea – Staffel 1
- Havoc (2025)
- Heart of Stone
- Heartbreak High – Staffel 1
- Heartstopper – Staffel 1
- Heartstopper – Staffel 2
- Heilige Familie – Staffel 1
- Heilige Familie – Staffel 2
- Heimgesucht: Unglaubliche Zeugenberichte – Staffel 1
- Heimgesucht: Unglaubliche Zeugenberichte – Staffel 2
- Heiratswillig
- Hell Camp: Teen Nightmare
- Hellbound – Staffel 1
- Hellhole (2022)
- Hero Mask – Staffel 1
- Herr Spaßmobil und die Tempelritter
- Herzensparade
- Herzschlag – Staffel 1
- Heute schläfst du mit mir
- Heweliusz
- Hier spricht Zodiac
- High Flying Bird
- High Score
- High Seas – Staffel 1
- High Seas – Staffel 2
- High: Bekenntnisse einer Drogenkuriererin
- Hilda – Staffel 1
- Hilda und der Bergkönig
- Hillbilly-Elegie
- His and Hers (2026)
- His House
- Hitler und die Nazis: Das Böse vor Gericht
- Hochwasser
- Hochzeitsreise
- Holidate
- Holiday Rush
- HollyBlood
- Hollywood
- Home Team
- Homecoming – Ein Film von Beyoncé
- Homemade – Ausgabe 1
- Homero Gómez González, Hüter der Monarchen
- Homicide: New York
- Homunculus
- Hoops – Staffel 1
- Horror am Dienstag – Staffel 1
- Horse Girl
- Hostage (2025)
- Hot Frosty
- Hot Skull
- Hot Wheels Let’s Race – Staffel 1
- House Arrest
- House of Guinness – Staffel 1
- House of Ninjas – Staffel 1
- How I Fell in Love with a Gangster
- How It Ends (2018)
- How to Be a Cowboy – Staffel 1
- How to Become a Cult Leader
- How to Become a Mob Boss
- How to Build a Sex Room – Staffel 1
- How To Get To Heaven From Belfast
- How to Rob a Bank
- How to Sell Drugs Online (Fast) – Staffel 1
- How to Sell Drugs Online (Fast) – Staffel 2
- Hubie Halloween
- Huge in France – Staffel 1
- Hühnerhase und der Hamster der Finsternis
- Humint
- Hunde – Staffel 1
- Hundehügel
- Hungrig
- Hurrikan Katrina – Leben nach der Sintflut
- Hustle
- Hypnotic (2021)
- I Am a Killer
- I Am A Stalker – Staffel 1
- I Am Not Okay with This – Staffel 1
- I Believe in Santa
- I Came By
- I Care a Lot
- I Used To Be Famous
- I’m Thinking of Ending Things
- Ibiza
- Ich bin Alle
- Ich habe gerade meinen Vater getötet
- Ich habe meinen Körper verloren
- Ich hasse Weihnachten – Staffel 1
- Ich hasse Weihnachten – Staffel 2
- Ich liebe dich, Spinner!
- Ich sehe was, was du nicht siehst
- Ich trau mich 100-mal
- Ich und die Walter Boys – Staffel 1
- Ich vermisse dich
- Ich. bin. so. glücklich.
- If Anything Happens I Love You
- If Wishes Could Kill
- iHostage
- Il Legame – Die Bindung
- Im Auge des Wolfes – Staffel 1
- Im Dreck – Staffel 1
- Im hohen Gras
- Im Namen Gottes: Heiliger Verrat
- Im Sumpf – Staffel 1
- Im Sumpf – Staffel 2
- Im Wasser der Seine
- Im Westen nichts Neues (2022)
- Immer für dich da – Staffel 1
- Immer noch nicht meine Liga
- In der Cyber-Hölle: Schrecken im Internet
- In der falschen Spur
- In die Tiefe: Der Mord auf dem U-Boot
- In ewiger Schuld
- In From the Cold – Staffel 1
- In guten Händen
- In guten Händen 2
- In Love and Deep Water
- In Luft aufgelöst: Der letzte große Banküberfall
- In seinen Händen (2025)
- In the Shadow of the Moon
- In Your Dreams – Im Traum ist alles möglich
- Incantation
- Incoming
- Indische Serienmörder: Der Schlächter von Delhi
- Indische Serienmörder: Tagebuch eines Killers
- Infamia
- Infiesto
- Innocence Project – Gerechtigkeit für Justitia
- Insatiable – Staffel 1
- Insel der Milliardäre – Staffel 1
- Inside Job – Staffel 1
- Inside Man (2022)
- Insiders – Staffel 1
- Instant Dream Home – Staffel 1
- Interceptor
- Into The Fire: Die verlorene Tochter
- Into the Night – Staffel 1
- Intrusion
- iNumber Number: Jozi Gold
- Invader Zim: Enter the Florpus
- Investigation Alien – Staffel 1
- IO
- Irgendwie schwanger
- Irish Wish
- IRL: In Real Love – Staffel 1
- Iron Chef: Quest for an Iron Legend – Staffel 1
- Is She the Wolf? – Staffel 1
- Is That Black Enough for You?!?
- Isi & Ossi
- Isn’t It Romantic
- Ist das Kuchen? – Staffel 1
- It’s Bruno! – Staffel 1
- Jack Whitehall: Weihnachten mit meinem Vater
- Jaguar – Staffel 1
- Jailbreak: Liebe auf der Flucht
- Jan de Lichte und seine Bande – Staffel 1
- Jay Kelly
- Je mehr, desto besser
- Jefe – Der Chef
- Jeffrey Dahmer: Selbstporträt eines Serienmörders
- Jeffrey Epstein: Stinkreich
- Jemand ist in deinem Haus
- Jemand muss sterben
- Jene Nacht
- Jennifer Lopez: Halbzeit
- Jennifers Tat
- Jenseits des Todes
- Jenseits des Universums
- Jentry Chau vs the Underworld – Staffel 1
- Jessica Jones – Staffel 1
- Jimmy Savile: Eine britische Horror-Story
- Jingle Bell Heist – Der große Weihnachtsraub
- Jingle Jangle Journey: Abenteuerliche Weihnachten!
- Jo Nesbo's Harry Hole – Staffel 1
- Jo Pil-ho: Der Anbruch der Rache
- Joe’s College Road Trip
- John Wayne Gacy: Selbstporträt eines Serienmörders
- Johnny
- Johnny Depp gegen Amber Heard
- Joint Venture – Staffel 1
- Joko Anwar’s Nightmares and Daydreams
- Joy (2018)
- Joy (2024)
- Ju-on: Origins – Staffel 1
- Juanita
- Julia Reichert: Der Traum vom Filmemachen
- JUNG_E: Gedächtnis des Krieges
- Jupiter’s Legacy – Staffel 1
- Jurassic World: Neue Abenteuer – Staffel 1
- Jusqu’ici tout va bien – Staffel 1
- Just Say Yes
- K.O.
- Kacken an der Havel – Staffel 1
- Kadaver
- Kal – Verlass mich nicht
- Kaleidoskop
- Kalifat – Staffel 1
- Kalina – Die Sehnsucht in mir
- Kämpferin im Untergrund
- Kämpferinnen
- Kangaroo Valley
- Kaos – Staffel 1
- Kapitäne von Weltklasse
- Karma (2025)
- Kasaba: Die Kleinstadt
- Kate
- Kathal: A Jackfruit Mystery
- Katla – Staffel 1
- Keep Breathing
- Kein böser Traum
- Kein Druck
- Kein Friede den Toten
- Kein Lebenszeichen
- Kein Mann für leichte Stunden
- Kernschmelze: Der Unfall von Three Mile Island
- Kho Gaye Hum Kahan
- Kidnapped: Der Fall Elizabeth Smart
- Kidnapping Stella
- Kids mit Köpfchen – Staffel 1
- Kill Boksoon
- Killer Sally
- Killer Soup – Staffel 1
- King of Stonks
- Kingdom – Staffel 1
- Kiss Me First
- Kitz – Staffel 1
- Klaus
- Klein-Sibirien
- Kleo – Staffel 1
- Kleo – Staffel 2
- Knokke Off – Staffel 1
- Kodachrome
- Kojoten
- Konferensen
- Könige des Betrugs
- Königinnen auf der Flucht
- Kopf an Kopf
- Körper in Flammen
- KPop Demon Hunters
- Krasse Pranks – Staffel 1
- Kübra – Staffel 1
- Kümmert euch um Maya
- Kuntilanak
- Küssen und andere lebenswichtige Dinge
- La Dolce Villa
- La Grande Classe: alles beim altem
- La Influencia – Böser Einfluss
- La Jefa – Die Chefin
- La Palma (2024)
- La Révolution – Staffel 1
- La tribu – Rhythmus liegt in der Familie
- La Vie scolaire – Schulalltag
- Ladies First (2017)
- Ladies First (2026)
- Ladies First: Eine Geschichte der Frauen im Hip-Hop
- Lady Chatterleys Liebhaber (2022)
- Lady Voyeur
- Land der Gewohnheit
- Land der Sünde
- Larva Island – Staffel 1
- Las últimas horas de Mario Biondo
- Lass los
- Last Hope – Teil 1
- Last Samurai Standing – Staffel 1
- Laufen. Reiten. Rodeo.
- Le Jeu – Nichts zu verbergen
- Le Roi des Ombres
- Léas 7 Leben – Staffel 1
- Leave the World Behind
- Lebe zweimal, liebe einmal
- Leben auf unserem Planeten – Staffel 1
- Leben mit Leoparden
- Left-Handed Girl
- Lefter: Die Geschichte der Fußballlegende Ordinarius
- Legends
- Leila – Staffel 1
- Leitfaden für die perfekte Familie
- Leo (2023)
- Letzter Aufruf für Istanbul
- Leute kommen und gehen
- Leviathan – Staffel 1
- Lhaka Sherpa, Königin der Berggipfel
- Liebe für Erwachsene
- Liebe garantiert
- Liebe macht blind – Staffel 1
- Liebe und Anarchie – Staffel 1
- Liebe, Sex und goop – Staffel 1
- Liebe²
- Liebes Kind
- Lieferung vor Weihnachten
- Life After Death with Tyler Henry – Staffel 1
- Life’s a Glitch with Julien Bam – Staffel 1
- Lift
- Limpia – Schwimm zu mir
- Lionheart
- Live Is Life
- Living with Yourself – Staffel 1
- Locke & Key – Staffel 1
- Locked In
- Lockwood & Co – Staffel 1
- Lohn der Angst (2024)
- Lonely Planet: Liebe in Marokko
- Long Story Short – Staffel 1
- Look Both Ways
- Lost Girls
- Lost in Starlight
- Lou (2022)
- Louis Theroux: Inside the Manosphere
- Love & Gelato
- Love 101 – Staffel 1
- Love and Leashes
- Love and Monsters
- Love Con Revenge: Die Rache der Betrogenen
- Love Hard
- Love In The Villa
- Love Is in the Air (2023)
- Love Like The Falling Petals
- Love Tactics 2
- Love Untangled
- Love Wedding Repeat
- Love, Death & Robots – Staffel 1
- Lover, Stalker, Killer
- Luccas Welt
- Lulli
- Luna Nera – Staffel 1
- Luna Park – Staffel 1
- Lupin – Teil 1
- Lust Stories
- Luther: The Fallen Sun
- Ma Rainey’s Black Bottom
- maboroshi
- Madame Claude
- Madea’s Destination Wedding
- Maestro
- Magie in Motown – Staffel 1
- Maid
- Major Grom: Der Pestdoktor
- Makaylas Stimme: Ein Brief an die Welt
- Make My Day – Staffel 1
- Making Fun – Staffel 1
- Mala influencia – Verbotene Liebe
- Malcolm & Marie
- Maldivas – Staffel 1
- Malevolent – Und das Böse existiert doch
- Malibu Rescue
- Malibu Rescue – Die nächste Welle
- Malibu Rescue – Die Serie – Staffel 1
- Malnazidos – Im Tal der Toten
- Man on Fire (2026)
- Man vs. Baby
- Man vs. Bee
- Mango
- Maniac (2018)
- Mank
- Manno-Pause – Staffel 1
- Mantis
- Marco Polo – Staffel 1
- Maria (2019)
- Maria (2024, Netflix)
- Marianne – Staffel 1
- Mark Cavendish: Never Enough
- Marked – Staffel 1
- Marmaduke (2022)
- Marriage Story
- Marry My Dead Body
- Mask Girl
- Masters of the Universe: Revelation – Teil 1
- Masters of the Universe: Revolution
- Maternal Instinct: Der Fall Taylor Parker
- Matogrosso
- Matrimillas
- Matrjoschka
- MaveriX – Staffel 1
- Maximale Ladung
- Maya und die Drei
- McGregor Forever
- Me Time
- Mea Culpa
- Mech Cadets – Staffel 1
- Medical Police – Staffel 1
- Medusa (2025)
- Meet Me Next Christmas
- Mein 40-jähriges Ich
- Mein Bruder, meine Schwester
- Mein Lehrer, der Krake
- Mein Name ist Vendetta
- Mein Schwager ist ein Vampir
- Mein Vater, der BTK-Killer
- Mein wundervolles Leben
- Mein WWE Main Event
- Meine Begegnung mit dem Bösen
- Meine beste Freundin Anne Frank
- Meine Freunde sind alle tot
- Meine ganz besondere Hochzeit – Staffel 1
- Meine Tochter
- Menschen in Angst
- Mercury 13
- MerPeople – Staffel 1
- Merry Happy Whatever – Staffel 1
- Merve macht ihr Ding
- Meskina – Ein hoffnungsloser Fall
- Message from the King
- Messiah – Staffel 1
- Metal Lords
- Metallkunst: Showdown am Schweißgerät – Staffel 1
- Metruk Adam – Der verlassene Mann
- MH370: Das verschwundene Flugzeug
- Michael Jackson: Das Urteil
- Midnight Mass
- Mignonnes
- Miss Americana
- Missing: Dead or Alive? – Staffel 1
- Mit den Wellen
- Mit eiserner Hand – Staffel 1
- Mit zitternden Händen
- Mitternacht im Pera Palace – Staffel 1
- Mittsommernacht
- Mixed by Erry
- Mixtape
- Mob War: Philadelphia vs. The Mafia
- Mogli: Legende des Dschungels
- Money Shot: The Pornhub Story
- Mononoke The Movie: Chapter II – The Ashes of Rage
- Mononoke the Movie: Phantom in the Rain
- Monster (2023)
- Monster Hunter: Legends of the Guild
- Monster: Die Geschichte von Ed Gein
- Monster: Die Geschichte von Lyle und Erik Menendez
- Monster! Monster?
- Mord an der Costa del Sol
- Mord in Monaco
- Mord, wie er im Buche steht
- Morgen kommt ein neuer Himmel
- Moriah Wilson: Die tragische Wahrheit
- Mosul
- Mother of the Bride
- Mother/Android
- Motorvalley – Staffel 1
- Moxie. Zeit, zurückzuschlagen
- Mr. Harrigan’s Phone
- Mr. Iglesias – Staffel 1
- Mr. McMahon
- Mrs Playmen
- Mudbound
- Mumbai-Mafia: Die Polizei gegen die Unterwelt
- Munafik 2
- München – Im Angesicht des Krieges
- Murali – Wie der Blitz
- Murder Mystery
- Murder Mystery 2
- Muscles & Mayhem: An Unauthorized Story of American Gladiators
- Mute
- Mütter der Pinguine – Staffel 1
- Muttertag (2023)
- My Holo Love
- My Little Pony: Eine neue Generation
- My Melody & Kuromi – Staffel 1
- My Name – Staffel 1
- My Name is Loh Kiwan
- My Oni Girl
- My Oxford Year
- My Secret Santa
- Mystère: Victorias geheimnisvoller Freund
- Mysteries of the Terracotta Warriors
- Mysterium Marilyn Monroe: Die ungehörten Bänder
- Nach der Razzia
- Naga
- Najmro
- Napad – Der Überfall
- Narcos – Staffel 1
- Narvik
- Neben der Spur
- Nelma Kodama: Königin der Geldwäsche
- Nemesis – Staffel 1
- Nepal im Schock: Die Folgen des Bebens am Mount Everest
- Néro – Staffel 1
- Neues aus der Welt
- Neureiche
- New Gods: Nezha Reborn
- Ni no Kuni
- Nice Girls – Einsatz in Nizza
- Nicht alles ist verhandelbar
- Nicht eine mehr
- Nicht meine Liga
- Nicht so fröhliche Weihnachten
- Nick für ungut – Staffel 1
- Nie meine Liga
- Niemand kommt hier lebend raus
- Niemand sah uns gehen
- Night Always Comes
- Night in Paradise
- Night Stalker: Auf der Jagd nach einem Serienmörder
- Night Teeth
- Nightbooks
- Nightflyers
- Nightmares of Nature: Wilde Horrorgeschichten – Staffel 1
- Nimona
- Nirgendwo (2023)
- No Good Deed – Staffel 1
- Nobody Sleeps in the Woods Tonight
- Nobody Sleeps in the Woods Tonight – Teil 2
- Nobody Wants This – Staffel 1
- Noch nie in meinem Leben ... – Staffel 1
- Nochmal Liebe²
- Noise (2023)
- Nonnas
- North of North – Staffel 1
- Northern Rescue – Staffel 1
- Notwehr
- Nr. 24
- Nur die halbe Geschichte
- Nur für dein Leben
- Nyad
- Obsession
- October Faction – Staffel 1
- Office Romance
- Officer Black Belt
- Oh, Ramona!
- Oje, ich wachse!
- Okja
- Old Dads
- Old People
- Ollies Odyssee
- Olympo – Staffel 1
- Omas Hochzeit
- Omnipräsenz – Staffel 1
- On My Block – Staffel 1
- On the Verge – Staffel 1
- One Day at a Time – Staffel 1
- One More Time
- One Piece – Staffel 1 (2023)
- One Shot with Ed Sheeran
- Onimusha – Staffel 1
- Onmyoji – Staffel 1
- Open Your Eyes – Staffel 1
- Operation Finale
- Operation Hyakinthos
- Operation Schwarze Krabbe
- Operation: Nation
- Orange Is the New Black – Staffel 1
- Orange Is the New Black – Staffel 2
- Orange Is the New Black – Staffel 3
- Orange Is the New Black – Staffel 4
- Orange Is the New Black – Staffel 5
- Orgasm Inc: The Story of OneTaste
- Orion und das Dunkel
- Osmosis – Staffel 1
- Otherhood
- Our Little Secret
- Outer Banks – Staffel 1
- Outlast – Staffel 1
- Outlaw King
- Outlaws (2021)
- Outside the Wire
- Oxygen
- Pachamama
- Pacto De Silencio – Staffel 1
- Paddleton
- Pain Hustlers
- Painkiller
- Pamela – Eine Liebesgeschichte
- Pandemie – Staffel 1
- Pangolin: Kulus Weg
- Papa gesucht
- Paradise (2023)
- Paradise Beach
- Paradise PD – Staffel 1
- Paradox (2018)
- Parallelwelten
- Paranormal – Staffel 1
- Parasyte: The Grey – Staffel 1
- Pasteleros contra el tiempo – Staffel 1
- Pavane
- Pax Massilia – Staffel 1
- Peaky Blinders: The Immortal Man
- Pedro Páramo (2024)
- Penny Dreadful – Staffel 1
- Penny Dreadful – Staffel 2
- Penny Dreadful – Staffel 3
- People We Meet on Vacation
- Pepsi, wo ist mein Jet?
- Per im Glück
- Perfect Match – Staffel 1
- Perfekt ist anders
- Perfil falso – Staffel 1
- Persona – Kollektion 1
- Pets United
- Pfadfinderehre: Die Geheimakten der Boy Scouts of America
- Pflicht/Schande – Staffel 1
- Phänomena
- Photocopier
- Pickpockets – Meister im Stehlen
- Pieces of a Woman
- Pinky Malinky – Staffel 1
- Pipa
- Pirates: Der Schatz des Königs
- Plagi Breslau – Die Seuchen Breslaus
- Plan A Plan B
- Plan Coeur: Der Liebesplan – Staffel 1
- Plan Coeur: Der Liebesplan – Staffel 2
- Planet Single: Greek Adventure
- Plankton: Der Film
- Platonisch
- Players
- Podlachien – Alle für eine
- Point Blank
- Pokémon – Der Film: Geheimnisse des Dschungels
- Pokémon: Die Arceus-Chroniken
- Pokémon: Mewtwo schlägt zurück – Evolution
- Polar
- Poldi
- Polo – Staffel 1
- Pose – Staffel 1
- Post Mortem: In Skarnes stirbt niemand – Staffel 1
- Power
- Pressure Cooker – Staffel 1
- Pretty Guardian Sailor Moon Cosmos: Der Film
- Prey (2021)
- Prime Time
- Prinz von Peoria – Teil 1
- Prinz von Peoria: Der magische Weihnachtselch
- Prinzessinnentausch
- Prinzessinnentausch 3: Auf der Jagd nach dem Stern
- Prinzessinnentausch: Wieder vertauscht
- Private Life
- Procession
- Project Power
- Projekt UFO
- Puffs Reich: Wunder des Riffs
- Pulse (2025) – Staffel 1
- Purple Hearts
- Rabbids Invasion Spezial: Mission zum Mars
- Rabo de Peixe – Staffel 1
- Rache ist süß – Staffel 1
- Raël: Der Prophet der Außerirdischen
- Ragnarök – Staffel 1
- Rainbow
- Raising Dion – Staffel 1
- Ram Dass, Going Home
- Ransom Canyon – Staffel 1
- Ratched – Staffel 1
- Räuber und Gendarm (2020)
- re:member
- Reality Check: Inside America’s Next Top Model
- Reality Z – Staffel 1
- Rebecca (2020)
- Rebel Moon – Teil 1: Kind des Feuers
- Rebel Moon – Teil 2: Die Narbenmacherin
- Rebel Ridge
- Rebelde: Jung und rebellisch – Staffel 1
- Recalé
- Recovery Boys – Jeder Versuch zählt
- Red Dot
- Red Notice
- Red Rose – Staffel 1
- Reich um jeden Preis
- Reichlich verliebt 2
- Reif für einen Mord
- Rein privat – Staffel 1
- Reingelegt! – Staffel 1
- Renault 4
- Rentierbaby
- Reptile
- Resident Evil – Staffel 1
- Resort to Love
- Rettet Bikini Bottom: Der Sandy Cheeks Film
- Rettungshund Ruby
- Revelations
- Rez Ball
- Rilakkuma und Kaoru – Staffel 1
- Rilakkumas Abenteuer im Vergnügungspark
- Rim of the World
- Ripley
- Rising Impact – Staffel 1
- Riverdance: Ein animiertes Abenteuer
- Roald Dahls Matilda – Das Musical
- Robbie Williams
- Robozuna – Staffel 1
- Rockos modernes Leben: Alles bleibt anders
- Rodeio Rock – Unverhofft kommt oft
- Rohwedder – Einigkeit und Mord und Freiheit
- Roma
- Ronaldinho: The One and Only
- Roommates
- Rough Diamonds – Staffel 1
- Roxanne Roxanne
- Royalteen
- Royalteen: Prinzessin Margrethe
- Rückkehr ins Weltall
- Ruhe in Frieden
- Rumspringa – Ein Amish in Berlin
- Run for the Money – Staffel 1
- Run Rabbit Run
- Running Point – Staffel 1
- Rustin
- Ruth & Boaz
- Sabrina (2018)
- Sackgasse
- Safe (2018)
- Sag mir wann
- Sahara (2017)
- Sahmaran – Staffel 1
- Saint Seiya: Die Krieger des Zodiac – Staffel 1
- Salir del ropero
- Salvador – Staffel 1
- Sanctuary – Staffel 1
- Sandman – Staffel 1
- Sans répit – Ruhelos
- Saras Tagebuch
- Savage Beauty – Staffel 1
- Schatten in meinen Augen
- Scheherazade
- Scheidung
- Schieb es nicht aufs Karma!
- Schlafende Hunde
- Schlummerland
- Schmutziges Pop-Geschäft: Der Boy-Band-Betrug
- Schnappt Gotti
- Schnelles Geld – Staffel 1
- Schon wieder Weihnachten
- Schulanfang für die Supermonster
- Schumacher
- Schwarm der Schrecken
- Schwarze Insel
- Schwestern im (Un)Glück
- Scoop – Ein royales Interview
- Scott Pilgrim hebt ab – Staffel 1
- Scrooge: Ein Weihnachtsmusical
- Sean Combs: The Reckoning
- Seaspiracy
- Secret Obsession
- See You Yesterday
- Sei lieb – Bete und gehorche
- Seitenwechsel
- Selbstbestimmung ./. Politik – Abtreibung in den USA
- Self Made: Das Leben von Madam C.J. Walker
- Selling Tampa – Staffel 1
- Selling the OC – Staffel 1
- Sen İnandır – Ich möchte dir glauben
- Senior Year
- Senna (2024)
- Sentinelle (2021)
- Senzo Meyiwa: Mord an einem Fußballstar
- Seoul Vibe
- Sergio
- Set It Up
- Setz’ aufs Leben – Staffel 1
- Seventeen
- Sex Education – Staffel 1
- Sex/Life – Staffel 1
- Sexify – Staffel 1
- Shadow and Bone: Legenden der Grisha – Staffel 1
- Shaft (2019)
- She Said Maybe
- She-Ra und die Rebellen-Prinzessinnen – Staffel 1
- Shiny_Flakes: The Teenage Drug Lord
- Shirley (2024)
- Should I Marry a Murderer?
- Sicherheit
- Sicilia Express
- Sick Note – Staffel 1
- Sie sehen dich
- Sie weiß von dir
- Sierra Burgess Is a Loser
- Silverton Siege
- Simone Biles: Wie ein Phönix aus der Asche
- Single All the Way
- Single und begehrt
- Sirens (2025)
- Skandal! Der Sturz von Wirecard
- Skater Girl
- Sky High
- Sky High: Die Serie – Staffel 1
- Sky Rojo – Staffel 1
- Skylines – Staffel 1
- Skywalkers: Eine Liebesgeschichte
- Sly
- Smiley
- Sneakerheads – Staffel 1
- Snowflake Mountain – Staffel 1
- Social Distance – Staffel 1
- Solo
- Someone Great
- Something Very Bad Is Going to Happen
- Son of Sam: Selbstporträt eines Serienmörders
- Song of the Bandits – Staffel 1
- Soni
- Sonic Prime – Staffel 1
- Soulcatcher
- Soundtrack – Staffel 1
- Sous emprise – Die Freiheit unter Wasser
- Sovdagari – Der Händler
- Space Force – Staffel 1
- Space Sweepers
- Spaceman: Eine kurze Geschichte der böhmischen Raumfahrt
- Spectros – Staffel 1
- Spellbound
- Spenser Confidential
- Spieglein, Spieglein
- Spieleabend
- Spinning Out – Staffel 1
- Spionageoperationen
- Spirit – wild und frei: Weihnachts-Spirit
- Splinter Cell: Deathwatch – Staffel 1
- SpongeBob Schwammkopf: Eine schwammtastische Rettung
- Spriggan – Staffel 1
- Spuk in Bly Manor
- Spuk in Hill House
- Spy Kids: Armageddon
- Squid Game – Staffel 1
- Squid Game – Staffel 2
- Squid Game: The Challenge – Staffel 1 (Folgen 1-5)
- Sr.
- Stadt der Schatten
- Stadtgeschichten
- Stand By Me Doraemon 2
- Stateless
- Steel Rain
- Sterbliche – Staffel 1
- Steve (2025)
- Stigma Monatsblutung
- Stolen: Der große Diamantenraub in Antwerpen
- Straw
- Ströme des Schicksals
- Stumm
- Stundenplan
- Stutz
- Subterran – Staffel 1
- Suche mich nicht
- Summer Job – Staffel 1
- Sunday’s Illness
- Supacell – Staffel 1
- Super Drags – Staffel 1
- Supersex
- Survival of the Thickest – Staffel 1
- Surviving Black Hawk Down – Die Schlacht von Mogadischu
- Surviving Paradise – Staffel 1
- Surviving Summer – Staffel 1
- Suzzanna: Buried Alive
- Svaha – The Sixth Finger
- Swap Shop – Staffel 1
- Swapped – Getauscht
- Sweet Bobby: Mein Catfishing-Albtraum
- Sweet Girl
- Sweet Tooth – Staffel 1
- Swordgai: The Animation – Staffel 1
- Tage wie diese
- Take That
- Take Your Pills
- Taktiken der Liebe
- Tanz der Unschuldigen
- Tanzen für den Teufel: Die TikTok-Sekte von 7M
- Tapie
- Tau
- Teach You a Lesson
- Team Kaylie – Teil 1
- Ted Bundy: Selbstporträt eines Serienmörders
- Teenage Bounty Hunters – Staffel 1
- Telekinese
- Temporada de Huracanes
- Terminator Zero – Staffel 1
- Territory – Staffel 1
- Terror in London: Die Jagd auf die Attentäter vom 7.7.
- Testament: Die Geschichte von Moses
- Tex Mex Motors – Staffel 1
- Texas Chainsaw Massacre (2022)
- That’s Amor
- The 8 Show
- The A List – Staffel 1
- The A List – Staffel 2
- The Abandons – Staffel 1
- The Adam Project
- The After Party
- The Anthrax Attacks
- The App
- The Apprentice: ONE Championship Edition - Staffel 1
- The Babysitter
- The Babysitter: Killer Queen
- The Ballad of Buster Scruggs
- The Bastard Son & The Devil Himself – Staffel 1
- The Beast in Me
- The Beautiful Game
- The Big Show Show – Staffel 1
- The Billion Dollar Code
- The Bleeding Edge – Das Geschäft mit der Gesundheit
- The Boroughs
- The Boss Baby: Weihnachtsbonus
- The Boss Baby: Wieder im Geschäft – Staffel 1
- The Boys in the Band
- The Brothers Sun – Staffel 1
- The Bubble
- The Call (2020)
- The Christmas Chronicles 2
- The Coldest Game
- The Crash: Wenn junge Liebe toxisch wird
- The Crew – Staffel 1
- The Curse of Bridge Hollow
- The Decameron
- The Deliverance
- The Devil All the Time
- The Devil's Plan – Staffel 1 (Folgen 1-4)
- The Dirt: Sie wollten Sex, Drugs & Rock’n’Roll
- The Drug King
- The Eddy
- The Electric State
- The Elixir
- The English Game
- The Expanding Universe of Ashley Garcia – Teil 1
- The Falls
- The Family
- The Father Who Moves Mountains
- The Forest of Love
- The Four Seasons (2025)
- The Frog
- The Gentlemen – Staffel 1
- The Glory – Staffel 1
- The Good Nurse
- The Gray Man
- The Great Flood
- The Greatest Night in Pop
- The Guardians of Justice – Staffel 1
- The Guilty (2021)
- The Hand of God
- The Harder They Fall
- The Hater
- The Highwaymen
- The Holiday Calendar
- The Hollow
- The House
- The I-Land
- The Imperfects – Staffel 1
- The In Between
- The Innocents – Staffel 1
- The Irishman
- The Journalist – Staffel 1
- The King
- The Kissing Booth
- The Kissing Booth 2
- The Kissing Booth 3
- The Kitchen
- The Knight Before Christmas
- The Kominsky Method – Staffel 1
- The Last Days of American Crime
- The Last Laugh
- The Last Mercenary
- The Last Summer
- The Lincoln Lawyer – Staffel 1
- The Madness
- The Makanai: Cooking for the Maiko House – Staffel 1
- The Man From Toronto
- The Man of God
- The Martha Mitchell Effect
- The Merry Gentlemen
- The Midnight Sky
- The Monkey King (2023)
- The Mother
- The New Yorker: Die ikonische Zeitschrift wird 100
- The Night Agent – Staffel 1
- The Night Agent – Staffel 2
- The Night Comes for Us
- The Noel Diary
- The Old Guard
- The Old Guard 2
- The One – Finde dein perfektes Match
- The Order – Staffel 1
- The Other Side of the Wind
- The Out-Laws
- The Outsider
- The Package (2018)
- The Pentaverate
- The Perfect Find
- The Perfect Neighbor – Ein Gesetz und seine Folgen
- The Perfection
- The Piano Lesson
- The Politician – Staffel 1
- The Power of the Dog
- The Price of Confession
- The Prom
- The Queen of Villains
- The Railway Men – The Untold Story of Bhopal 1984
- The Rain – Staffel 1
- The Real Bling Ring: Hollywood Heist
- The Recruit – Staffel 1
- The Red Sea Diving Resort
- The Residence
- The Returned – Staffel 1 (2015)
- The Rip
- The Ritual
- The Royal Treatment
- The School for Good and Evil
- The School Nurse Files – Staffel 1
- The Seven Deadly Sins – Staffel 1
- The Seven Deadly Sins: Four Knights of the Apocalypse – Staffel 1
- The Silent Sea – Staffel 1
- The Six Triple Eight
- The Sleepover
- The Society – Staffel 1
- The Spy
- The Stranger
- The Strays
- The Survivors – Der Sturm
- The Takeover
- The Thursday Murder Club
- The Trial of the Chicago 7
- The Trust: A Game of Greed – Staffel 1 (Folgen 1-4)
- The Ultimatum: Marry or Move On – Staffel 1
- The Ultimatum: Marry or Move On – Staffel 2
- The Umbrella Academy – Staffel 1
- The Umbrella Academy – Staffel 2
- The Unforgivable
- The Union
- The Unlisted – Staffel 1
- The Valhalla Murders
- The Watcher
- The Water Man
- The Waterfront – Staffel 1
- The Weekend Away
- The Whole Truth (2021)
- The Witcher – Staffel 1
- The Witcher: Blood Origin
- The Witcher: Sirens of the Deep
- The Witness (2026)
- The Woman in Cabin 10
- The Woman in the House Across the Street From the Girl in the Window
- The Woman in the Window
- The WONDERfools
- The Wrong Missy
- The Wrong Paris
- The Yin Yang Master
- The Yin-Yang Master: Dream of Eternity
- Thelma, das Einhorn
- They Cloned Tyrone
- Things Heard & Seen
- Thrash
- Three Days of Christmas
- Through my Window – Ich sehe nur dich
- Through my Window – Über das Meer
- Through my Window 3 – Ich seh’ dich an
- Thunder Force
- Tick, Tick... Boom!
- Tief im Herzen
- Tiger King: Großkatzen und ihre Raubtiere
- Tigertail
- Tijuana – Staffel 1
- Til Death Do Us Part – Staffel 1
- Time Cut
- Time Share
- Time to Hunt
- Tin & Tina
- Tires – Staffel 1
- Titan: Die OceanGate-Katastrophe
- Titletown High – Staffel 1
- To All the Boys I’ve Loved Before
- To All The Boys: Always And Forever
- To All the Boys: P.S. I Still Love You
- Tod vor der Hochzeit
- Tödlich: Eine amerikanische Ehe
- Tödliche Einladung
- Togo (2022)
- Tomb Raider: The Legend of Lara Croft – Staffel 1
- Top Boy – Staffel 1
- Top Secret UFO Projects: Declassified
- Toskana
- Töte mich nicht
- Töte mich, wenn du dich traust
- Totenfrau – Staffel 1
- Tour de France: Im Hauptfeld – Staffel 1
- Toxic Town
- Tragic Jungle
- Trailer Park Boys: The Animated Series – Staffel 1
- Train Dreams
- Trainwreck: Chaos-Bürgermeister
- Trainwreck: Der American Apparel-Kult
- Trainwreck: Der Ballon-Junge
- Trainwreck: Der Sturm auf Area 51
- Trainwreck: Die echte Project-X-Party
- Trainwreck: P.I. Moms
- Trainwreck: Poop Cruise
- Trainwreck: Tragödie beim Astroworld-Festival
- Transatlantic
- Treason
- Trees of Peace
- Trial by Fire
- Tribes of Europa – Staffel 1
- Trigger (2025)
- Trigger Warning
- Trigger Warning with Killer Mike – Staffel 1
- Triple Frontier
- Trippin’ with the Kandasamys
- Troll (2022)
- Troll 2 (2025)
- Trotz allem
- True Haunting: Wahre Horrorgeschichten – Staffel 1
- True Spirit
- True Story
- Trump: An American Dream
- Tu hijo – Sohn der Vergeltung
- Tuca & Bertie – Staffel 1
- Tuiskoms – Willkommen in Wilderness
- Turn Up Charlie – Staffel 1
- Twilight of the Gods – Staffel 1
- Twister: Im Sturm gefangen
- Two Distant Strangers
- Tyler Rake: Extraction
- Tyler Rake: Extraction 2
- UFO – Unidentified Forgotten Object
- Ugly – Verlier nicht dein Gesicht
- Ultraman – Staffel 1
- Ultraman: Rising
- Um die Welt mit Zac Efron – Staffel 1
- Um ein Schnurrhaar
- Unbekannt: Die Knochenhöhle
- Unbekannt: Die kosmische Zeitmaschine
- Unbekannt: Die vergessene Pyramide
- Unbekannt: Killerroboter
- Unbekannte Nummer: Der Highschool-Catfish
- Unbelievable
- Unchosen – Staffel 1
- Uncorked
- Uncoupled – Staffel 1
- Und atmen Sie normal weiter
- Undercover im Seniorenheim – Staffel 1
- Unfamiliar – Staffel 1
- Unfrosted
- Unicorn Store
- Unlocked: A Jail Experiment
- Unorthodox
- Unsagbare Sünden – Staffel 1
- Unseen – Staffel 1
- Unser Paris
- Unser Vater – Dr. Cline
- Unsere wunderbaren Nationalparks
- Unsolved Mysteries – Ausgabe 1
- Unsportlich – Staffel 1
- Unstable – Staffel 1
- Untamed
- Unten am Fluss (2018)
- Unter der schwarzen Sonne
- Unter der Sonne Amalfis
- Unter der Sonne Ricciones
- Untergegangenen Zivilisationen auf der Spur – Staffel 1
- Untold: Breaking Point
- Untold: Caitlyn Jenner
- Untold: Chess Mates
- Untold: Crimes and Penalties
- Untold: Deal with the Devil
- Untold: Hall of Shame
- Untold: Hope Solo vs. U.S. Soccer
- Untold: Jake Paul the Problem Child
- Untold: Johnny Football
- Untold: Malice at the Palace
- Untold: Operation Flagrant Foul
- Untold: Shooting Guards
- Untold: Sign Stealer
- Untold: Swamp Kings
- Untold: The Death & Life of Lamar Odom
- Untold: The Fall of Favre
- Untold: The Girlfriend Who Didn't Exist
- Untold: The Liver King
- Untold: The Murder of Air McNair
- Untold: The Race of the Century
- Untold: The Rise and Fall of AND1
- Uprising
- Urteilsverlust – Staffel 1
- Us and Them
- USA 94: Brasiliens Rückkehr an die Spitze
- V Wars – Staffel 1
- Vampires – Staffel 1
- Vampires vs. the Bronx
- Vater des Jahres
- Vendetta: Wahrheit, Lügen und die Mafia – Staffel 1
- Verbrechen verbindet
- Verbündete Feinde
- Vergib uns unsere Schuld
- Vergiftet: Die schmutzige Wahrheit über unser Essen
- Verirrte Kugel
- Verirrte Kugel 2
- Verirrte Kugel 3
- Verloren
- Verlorene Liebe
- Verräter – Staffel 1
- Verrückt nach ihr
- Verrückter Planet – Staffel 1
- Verschwunden in die Nacht
- Verschwunden in Lørenskog
- Verschwunden: Der Fall Lucie Blackman
- Verschwunden: Tatort Cecil Hotel
- Verstecken ist vergebens – Staffel 1
- Verstrickt in Lügen: Die Geschichte von César Román
- Vertrau mir: Der falsche Prophet
- Vertraue niemandem: Die Jagd nach dem Kryptokönig
- Vetala – Staffel 1
- Victim/Suspect
- Victoria Beckham
- Vier Gäste
- Viking Wolf
- Violet Evergarden
- Virgin River – Staffel 1
- Viva a Vida – Auf das Leben
- Vivo – Voller Leben
- Vizinhos – Nachbarn
- Vjeran Tomic: Der Spiderman von Paris
- Vladimir
- Voces – Die Stimmen
- Voicemails for Isabelle
- Voir: Die Filmkunst in der Moderne – Staffel 1
- Voll mutiert: Fußballcup in Gefahr
- Völlig zerstört – Staffel 1
- Vom Rockstar zum Killer: Der Fall Bertrand Cantat
- Vom Traum zur Tragödie
- Vor wem laufen wir eigentlich davon? – Staffel 1
- Waco: Amerikanische Apokalypse
- Wage es nicht – Staffel 1
- Wake Up Dead Man: A Knives Out Mystery
- Wallace & Gromit: Vergeltung mit Flügeln
- Wand an Wand
- Wanna Marchi: Die Fernsehbetrügerin
- War Machine (2026)
- War Sailor
- Warrior Nun – Staffel 1
- Warriors of Future
- Warum hast du mich getötet?
- Was für ein schönes Wochenende!
- Was geschah mit dem Delfin-König?
- Was Hunde denken
- Was Katzen denken
- Was wir wollten
- Wasp Network
- Wayward – Unberechenbar
- We Can Be Heroes
- We Have a Ghost
- Weathering
- Web of Make Believe: Tod, Lügen und das Internet – Staffel 1
- Wedding Season
- Wednesday – Staffel 1
- Weihnachten auf der Mistelzweigfarm
- Weihnachten in der Wildnis
- Weihnachten mal anders
- Weihnachten mit Familienanhang
- Weihnachten mit Graça
- Weihnachten zu Hause – Staffel 1
- Weihnachten zu Hause – Staffel 2
- Weihnachten zu Hause – Staffel 3
- Weil der Mensch erbärmlich ist
- Weißes Meer: Die surreale Story von Rabo de Peixe
- Weißes Rauschen
- Wellmania – Staffel 1
- Wen würdest du auf eine einsame Insel mitnehmen?
- Wendell & Wild
- Wendepunkt: 9/11 und der Krieg gegen den Terror – Staffel 1
- Wendepunkt: Die Bombe und der Kalte Krieg
- Wenn jede Sekunde zählt: Londons Trauma-Netzwerk
- Wer einmal lügt
- Wer hat den kleinen Grégory getötet?
- Wer hat Malcolm X umgebracht?
- Wer hat Sara ermordet? – Staffel 1
- Wer ist am schnellsten? – Staffel 1
- Westside – Staffel 1
- Wham!
- What Did Jack Do?
- What/If – Staffel 1
- When Angels Sleep
- When They See Us
- White Lines – Staffel 1
- Who Is Erin Carter?
- Who Killed Santa? A Murderville Murder Mystery
- Why Are You Like This – Staffel 1
- Wie der Vater
- Wie ein Tanz auf Glas
- Wie ich ein Superheld wurde
- Wie Jodi über sich hinauswuchs
- Wie Jodi über sich hinauswuchs 2
- Wie man Weihnachten verhunzt – Staffel 1
- Wie wird man 100 Jahre alt? – Die Geheimnisse der Blauen Zonen
- Wieder 15 – Staffel 1
- Wild Croc Territory – Staffel 1
- Wild Wild Country
- Wilde Babys – Staffel 1
- Wilde Kräuter
- Willkommen auf Eden – Staffel 1
- Willkommen bei den Louds: Der Film
- Willkommen in der Familie
- Windfall
- Wine Country
- Winterbucht
- Wir können nicht anders
- Wir konnten nicht erwachsen werden
- Wir sind die Welle – Staffel 1
- Wir waren Könige (2024)
- Wir waren wie Lieder
- Wo die Erde bebt
- Wo ist Marta?
- Wolfsnächte
- Wolkenbruchs wunderliche Reise in die Arme einer Schickse
- Woody Woodpecker geht ins Camp
- Work It
- Workin’ Moms – Staffel 1
- Worst Ex Ever – Staffel 1
- Wounds
- Wrestlers – Staffel 1
- Wu Assassins – Staffel 1
- Wyatt Earp and the Cowboy War
- Yakamoz S-245 – Staffel 1
- Yaksha: Ruthless Operations
- Yakuza Goes Hausmann – Staffel 1
- Yara
- Yes Day
- Yiya Murano: Tod am Nachmittag
- Yoh! Christmas – Staffel 1
- You – Du wirst mich lieben – Staffel 1
- You – Du wirst mich lieben – Staffel 2
- You Don’t Know Me
- You People
- Young Millionaires
- Young Royals – Staffel 1
- Your Place or Mine
- Yu Yu Hakusho – Staffel 1 (2023)
- Yucatán
- Zeig mir, wer du bist
- Zeit der Geheimnisse
- Zeitalter der Samurai: Kampf um Japan
- Zelle 211 (2025)
- Zero – Staffel 1
- Zero Chill – Staffel 1
- Zero Day
- Zero to Hero
- Ziam
- Zion
- Zoe und Raven: Es weihnachtet sehr
- Zoe und Raven: Valentinstag
- Zom 100: Bucket List of the Dead
- Zuhause bei den Furys – Staffel 1
- Zurück ins Outback
- Zwei
- Zwei an einem Tag (2024)
- Zwei Bullen auf Ziegenjagd
- Zwei Gräber
- Zwei Sommer – Staffel 1
- Zwei wie Pech und Schwefel (2022)
- Zwischen zwei Farnen: Der Film
Bei diesen Links handelt es sich um sogenannte Affiliate-Links. Bei einem Kauf über diesen Link erhalten wir eine Provision, ohne dass für euch Mehrkosten entstehen. Auf diese Weise könnt ihr unsere Seite unterstützen.
(Anzeige)